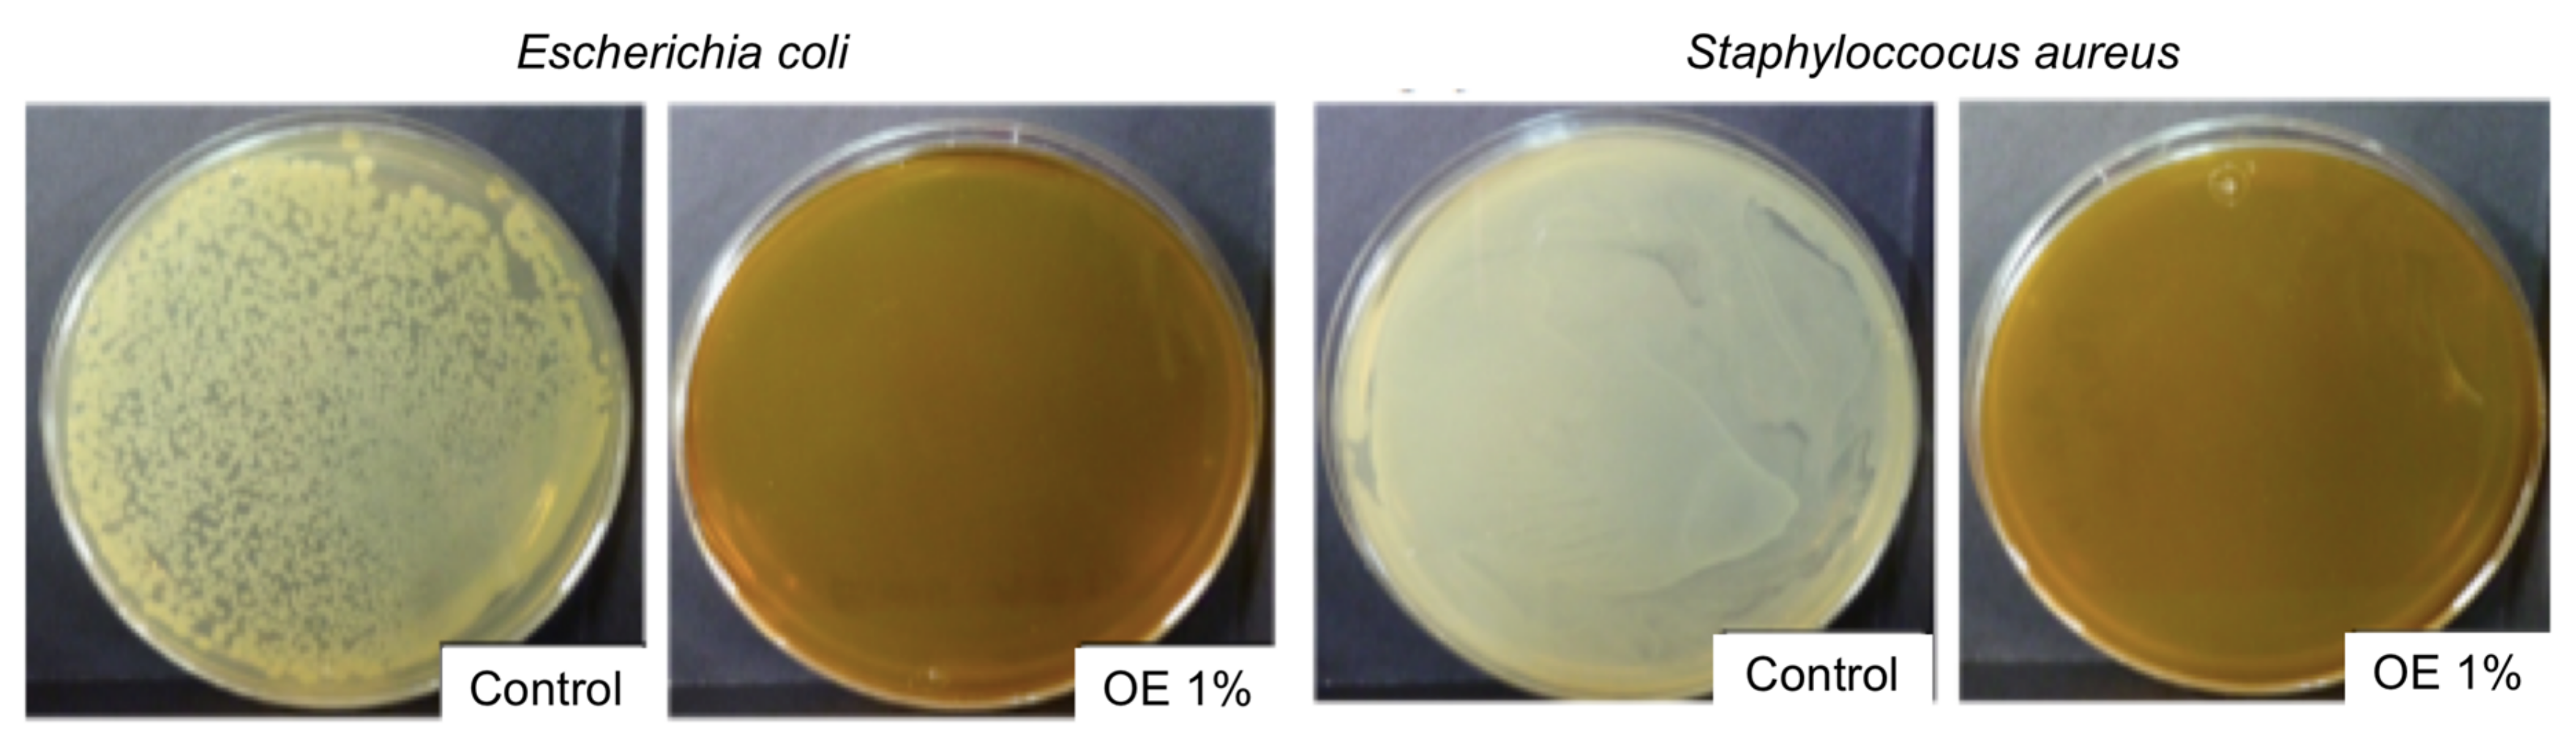
Foods 09 01339 g001

Impact of Olive Extract Addition on Corn Starch-Based Active Edible Films Properties for Food Packaging Applications
Abstract
1. Introduction
2. Materials and Methods
2.1. Materials
2.2. Olive Extract Characterization
2.2.1. Total Phenolic Content (TPC)
2.2.2. Total Flavonoid Content (TFC)
2.2.3. In Vitro Antioxidant Activity Assays
2.2.4. Antimicrobial Activity
2.2.5. Attenuated Total Reflectance-Fourier Transform Infrared Spectroscopy (ATR-FTIR)
2.2.6. Thermal Stability
2.3. Preparation of Edible Films
2.4. Characterization of Edible Films
2.4.1. Thickness and Color Measurement
2.4.2. Structural Characterization
2.4.3. Thermal Characterization
2.4.4. Mechanical Properties
2.4.5. Barrier Properties
2.5. Antioxidant Activity of Edible Films
2.6. Antimicrobial Activity of Edible Films
2.7. Statistical Analysis
3. Results and Discussion
3.1. Olive Extract Characterization
3.1.1. Antioxidant Activity, TPC and TFC
3.1.2. Antimicrobial Activity
3.1.3. ATR-FTIR
3.1.4. Thermal Characterization
3.2. Characterization of Edible Films
3.2.1. Visual Appearance, Thickness and Color
3.2.2. Structural Characterization by ATR-FTIR
3.2.3. Thermal Characterization
3.2.4. Mechanical and Barrier Properties
3.3. Antioxidant Activity
3.4. Antimicrobial Activity
4. Conclusions
Author Contributions
Funding
Acknowledgments
Conflicts of Interest
References
- European Bioplastics. Bioplastics Market Data. 2020. Available online: https://www.european-bioplastics.org/market/ (accessed on 14 July 2020).
- García, A.V.; Ramos, M.; Beltrán, A.; Jiménez, A.; Garrigós, M. State of the Art of Antimicrobial Edible Coatings for Food Packaging Applications. Coatings 2017, 7, 56. [Google Scholar] [CrossRef]
- Mellinas, C.; Valdés, A.; Ramos, M.; Burgos, N.; Garrigós, M.; Jiménez, A. Active edible films: Current state and future trends. J. Appl. Polym. Sci. 2015, 133, 133. [Google Scholar] [CrossRef]
- Fakhouri, F.M.; Martelli, S.M.; Caon, T.; Velasco, J.I.; Mei, L.H.I. Edible films and coatings based on starch/gelatin: Film properties and effect of coatings on quality of refrigerated Red Crimson grapes. Postharvest Biol. Technol. 2015, 109, 57–64. [Google Scholar] [CrossRef]
- Galus, S.; Kadzińska, J. Food applications of emulsion-based edible films and coatings. Trends Food Sci. Technol. 2015, 45, 273–283. [Google Scholar] [CrossRef]
- Umaraw, P.; Munekata, P.E.; Verma, A.K.; Barba, F.J.; Singh, V.; Kumar, P.; Lorenzo, J.M. Edible films/coating with tailored properties for active packaging of meat, fish and derived products. Trends Food Sci. Technol. 2020, 98, 10–24. [Google Scholar] [CrossRef]
- Tahir, H.E.; Zou, X.; Mahunu, G.K.; Arslan, M.; Abdelhai, M.H.; ZhiHua, L. Recent developments in gum edible coating applications for fruits and vegetables preservation: A review. Carbohydr. Polym. 2019, 224, 115141. [Google Scholar] [CrossRef] [PubMed]
- Galus, S.; Kibar, E.A.A.; Gniewosz, M.; Kraśniewska, K. Novel Materials in the Preparation of Edible Films and Coatings—A Review. Coatings 2020, 10, 674. [Google Scholar] [CrossRef]
- Kumar, H.; Bhardwaj, K.; Sharma, R.; Nepovimova, E.; Kuca, K.; Dhanjal, D.S.; Verma, R.; Bhardwaj, P.; Sharma, S.; Kumar, D. Fruit and Vegetable Peels: Utilization of High Value Horticultural Waste in Novel Industrial Applications. Molecules 2020, 25, 2812. [Google Scholar] [CrossRef]
- Valencia, G.A.; Zare, E.N.; Makvandi, P.; Gutiérrez, T.J. Self-Assembled Carbohydrate Polymers for Food Applications: A Review. Compr. Rev. Food Sci. Food Saf. 2019, 18, 2009–2024. [Google Scholar] [CrossRef]
- Seligra, P.G.; Jaramillo, C.M.; Famá, L.; Goyanes, S. Biodegradable and non-retrogradable eco-films based on starch–glycerol with citric acid as crosslinking agent. Carbohydr. Polym. 2016, 138, 66–74. [Google Scholar] [CrossRef] [PubMed]
- Cano, A.; Jiménez, A.; Cháfer, M.; Gonzalez, C.; Chiralt, A. Effect of amylose:amylopectin ratio and rice bran addition on starch films properties. Carbohydr. Polym. 2014, 111, 543–555. [Google Scholar] [CrossRef]
- Vamadevan, V.; Bertoft, E. Structure-function relationships of starch components. Starch Stärke 2014, 67, 55–68. [Google Scholar] [CrossRef]
- Chollakup, R.; Pongburoos, S.; Boonsong, W.; Khanoonkon, N.; Kongsin, K.; Sothornvit, R.; Sukyai, P.; Sukatta, U.; Harnkarnsujarit, N. Antioxidant and antibacterial activities of cassava starch and whey protein blend films containing rambutan peel extract and cinnamon oil for active packaging. LWT 2020, 130, 109573. [Google Scholar] [CrossRef]
- Mendes, J.; Norcino, L.; Martins, H.; Manrich, A.; Otoni, C.; Carvalho, E.; Piccoli, R.; Oliveira, J.; Pinheiro, A.; Mattoso, L. Correlating emulsion characteristics with the properties of active starch films loaded with lemongrass essential oil. Food Hydrocoll. 2020, 100, 105428. [Google Scholar] [CrossRef]
- Souza, A.; Goto, G.; Mainardi, J.; Coelho, A.C.V.; Tadini, C. Cassava starch composite films incorporated with cinnamon essential oil: Antimicrobial activity, microstructure, mechanical and barrier properties. LWT 2013, 54, 346–352. [Google Scholar] [CrossRef]
- Falcão, H.A.D.S.; Filho, J.G.D.O.; Egea, M.B.; Da Silva, E.R.; Macagnan, D.; Pires, M.C.; Peixoto, J.R. Active film incorporated with clove essential oil on storage of banana varieties. Nutr. Food Sci. 2019, 49, 911–924. [Google Scholar] [CrossRef]
- Jiménez, A.; Sánchez-González, L.; Desobry, S.; Chiralt, A.; Tehrany, E.A. Influence of nanoliposomes incorporation on properties of film forming dispersions and films based on corn starch and sodium caseinate. Food Hydrocoll. 2014, 35, 159–169. [Google Scholar] [CrossRef]
- Ali, A.; Yu, L.; Liu, H.; Khalid, S.; Meng, L.; Chen, L. Preparation and characterization of starch-based composite films reinforced by corn and wheat hulls. J. Appl. Polym. Sci. 2017, 134, 45159. [Google Scholar] [CrossRef]
- Basiak, E.; Lenart, A.; Debeaufort, F. Effect of starch type on the physico-chemical properties of edible films. Int. J. Biol. Macromol. 2017, 98, 348–356. [Google Scholar] [CrossRef]
- Yu, Z.; Alsammarraie, F.K.; Nayigiziki, F.X.; Wang, W.; Vardhanabhuti, B.; Mustapha, A.; Lin, M. Effect and mechanism of cellulose nanofibrils on the active functions of biopolymer-based nanocomposite films. Food Res. Int. 2017, 99, 166–172. [Google Scholar] [CrossRef]
- Valdés, A.; Mellinas, A.C.; Ramos, M.; Garrigós, M.C.; Jiménez, A. Natural additives and agricultural wastes in biopolymer formulations for food packaging. Front. Chem. 2014, 2, 6. [Google Scholar] [CrossRef] [PubMed]
- Zhang, S.; Zhao, H. Preparation and properties of zein–rutin composite nanoparticle/corn starch films. Carbohydr. Polym. 2017, 169, 385–392. [Google Scholar] [CrossRef] [PubMed]
- Silva-Weiss, A.; Bifani, V.; Ihl, M.; Sobral, P.; Gómez-Guillén, M.C. Polyphenol-rich extract from murta leaves on rheological properties of film-forming solutions based on different hydrocolloid blends. J. Food Eng. 2014, 140, 28–38. [Google Scholar] [CrossRef]
- Hanumantharaju, K.; Thangavel, K.; Amirtham, D.; Rajamani, K. Physical properties and optimization of bio film prepared with corn starch and Justicia adhatoda leaf extract. Med. Plants Int. J. Phytomed. Relat. Ind. 2019, 11, 313. [Google Scholar] [CrossRef]
- Ochoa, T.A.; Almendárez, B.E.G.; Amaro-Reyes, A.; Pastrana, D.M.R.; López, G.F.G.; Martín-Belloso, O.; Regalado-González, C. Design and Characterization of Corn Starch Edible Films Including Beeswax and Natural Antimicrobials. Food Bioprocess Technol. 2016, 10, 103–114. [Google Scholar] [CrossRef]
- Krishnan, K.R.; Babuskin, S.; Rakhavan, K.; Tharavin, R.; Babu, P.A.S.; Sivarajan, M.; Sukumar, M. Potential application of corn starch (CS) edible films with spice essential oils for the shelf life extension of red meat. J. Appl. Microbiol. 2015, 119, 1613–1623. [Google Scholar] [CrossRef]
- Wang, X.; Kong, D.; Ma, Z.; Zhao, R. Effect of carrot puree edible films on quality preservation of fresh-cut carrots. Ir. J. Agric. Food Res. 2015, 54, 64–71. [Google Scholar] [CrossRef]
- Mallick, N.; Soni, A.; Pal, D. Improving the Mechanical, Water Vapor Permeability, Antimicrobial properties of Corn-Starch/Poly Vinyl Alcoholfilm (PVA): Effect of Rice husk fiber (RH) & Alovera gel(AV). In Proceedings of the National Conference on Advanced Materials and Applications (NCAMA 2019), Raipur, India, 21–22 December 2019; Conference Series: Materials Science and Engineering: Raipur, India, 2020; Volume 798, p. 12002. [Google Scholar] [CrossRef]
- FAOSTAT Database. Food and Drug Administration. 2020. Available online: http://www.fao.org/faostat/es/#data (accessed on 11 July 2020).
- Pereda, M.; Dufresne, A.; Aranguren, M.I.; Marcovich, N.E. Polyelectrolyte films based on chitosan/olive oil and reinforced with cellulose nanocrystals. Carbohydr. Polym. 2014, 101, 1018–1026. [Google Scholar] [CrossRef]
- Baraiya, N.S.; Rao, T.V.R.; Thakkar, V.R. Enhancement of storability and quality maintenance of carambola (Averrhoa carambola L.) fruit by using composite edible coating. Fruits 2014, 69, 195–205. [Google Scholar] [CrossRef]
- Khalifa, I.; Barakat, H.; El-Mansy, H.A.; Soliman, S.A. Effect of Chitosan-Olive Oil Processing Residues Coatings on Keeping Quality of Cold-Storage Strawberry (Fragaria ananassa. Var. Festival). J. Food Qual. 2016, 39, 504–515. [Google Scholar] [CrossRef]
- Hasan, M.; Rusman, R.; Khaldun, I.; Ardana, L.; Mudatsir, M.; Fansuri, H. Active edible sugar palm starch-chitosan films carrying extra virgin olive oil: Barrier, thermo-mechanical, antioxidant, and antimicrobial properties. Int. J. Biol. Macromol. 2020, 163, 766–775. [Google Scholar] [CrossRef] [PubMed]
- de Fernandez, M.D.L.A.; SotoVargas, V.C.; Silva, M.F. Phenolic Compounds and Antioxidant Capacity of Monovarietal Olive Oils Produced in Argentina. J. Am. Oil Chem. Soc. 2014, 91, 2021–2033. [Google Scholar] [CrossRef]
- Jeevahan, J.; Chandrasekaran, M. Effect of Olive oil Concentrations on film properties of edible composite films prepared from Corn starch and Olive oil. Res. J. Pharm. Technol. 2018, 11, 4934. [Google Scholar] [CrossRef]
- Hassen, I.; Casabianca, H.; Hosni, K.; Hassen, I. Biological activities of the natural antioxidant oleuropein: Exceeding the expectation—A mini-review. J. Funct. Foods 2015, 18, 926–940. [Google Scholar] [CrossRef]
- Gentile, L.; Uccella, N.A. Selected bioactives from callus cultures of olives (Olea europaea L. Var. Coratina) by LC-MS. Food Res. Int. 2014, 55, 128–136. [Google Scholar] [CrossRef]
- EP2170090B1 Patent. Hydroxytyrosol Fortified Oils and Their Uses. Probelte Pharma, S.A. 2012. Available online: https://patents.google.com/patent/EP2170090B1/tr (accessed on 18 July 2020).
- Swain, T.; Hillis, W.E. The phenolic constituents ofPrunus domestica. I.—The quantitative analysis of phenolic constituents. J. Sci. Food Agric. 1959, 10, 63–68. [Google Scholar] [CrossRef]
- Zhishen, J.; Mengcheng, T.; Jianming, W. The determination of flavonoid contents in mulberry and their scavenging effects on superoxide radicals. Food Chem. 1999, 64, 555–559. [Google Scholar] [CrossRef]
- Badarinath, A.V.; Rao, K.M.; Chetty, C.M.S.; Ramkanth, S.; Rajan, T.V.S.; Gnanaprakash, K. A review on In-vitro antioxidant methods: Comparisions, correlations and considerations. Int. J. PharmTech. Res. 2010, 2, 1276–1285. [Google Scholar]
- Alam, M.N.; Bristi, N.J.; Rafiquzzaman, M. Review on in vivo and in vitro methods evaluation of antioxidant activity. Saudi Pharm. J. 2012, 21, 143–152. [Google Scholar] [CrossRef]
- Molyneux, P. The use of the stable free radical diphenylpicryl-hydrazyl (DPPH) for estimating antioxidant activity. Songklanakarin J. Sci. Technol. 2004, 26, 211–219. [Google Scholar]
- Benzie, I.F.; Strain, J. The Ferric Reducing Ability of Plasma (FRAP) as a Measure of “Antioxidant Power”: The FRAP Assay. Anal. Biochem. 1996, 239, 70–76. [Google Scholar] [CrossRef]
- Re, R.; Pellegrini, N.; Proteggente, A.; Pannala, A.; Yang, M.; Rice-Evans, C. Antioxidant activity applying an improved ABTS radical cation decolorization assay. Free Radic. Biol. Med. 1999, 26, 1231–1237. [Google Scholar] [CrossRef]
- Ramírez, S.G.; López, O.B.; Guzmán, T.H.; Munguía, S.U.; Espinosa, S.Z. Actividad antifúngica in vitro de extractos de Origanum vulgare L., Tradescantia spathacea Swartz y Zingiber officinale Roscoe sobre Moniliophthora roreri (Cif & Par) Evans et ál. Tecnología En Marcha 2011, 24, 3–17. [Google Scholar]
- Janakat, S.; Al-Nabulsi, A.A.R.; Allehdan, S.; Olaimat, A.N.; Holley, R.A. Antimicrobial activity of amurca (olive oil lees) extract against selected foodborne pathogens. Food Sci. Technol. 2015, 35, 259–265. [Google Scholar] [CrossRef]
- Valdés, A.; Garcia-Serna, E.; Martínez-Abad, A.; Vilaplana, F.; Jiménez, A.; Garrigós, M. Gelatin-Based Antimicrobial Films Incorporating Pomegranate (Punica granatum L.) Seed Juice by-Product. Molecules 2019, 25, 166. [Google Scholar] [CrossRef] [PubMed]
- Jagadish, R.; Divyashree, K.; Viswanath, P.; Srinivas, P.; Raj, B. Preparation of N-vanillyl chitosan and 4-hydroxybenzyl chitosan and their physico-mechanical, optical, barrier, and antimicrobial properties. Carbohydr. Polym. 2012, 87, 110–116. [Google Scholar] [CrossRef]
- Tham, W.L.; Poh, B.T.; Ishak, Z.A.M.; Chow, W.S. Transparent poly(lactic acid)/halloysite nanotube nanocomposites with improved oxygen barrier and antioxidant properties. J. Therm. Anal. Calorim. 2016, 126, 1331–1337. [Google Scholar] [CrossRef]
- ASTM D882-09 Standard. Standard Test Method for Tensile Properties of Thin Plastic Sheeting. Available online: https://www.madcad.com/library/ASTM-D882-09/ (accessed on 22 September 2020).
- UNE-EN ISO 868:2003 Standard. Plastics and Ebonite—Determination of Indentation Hardness by Means of a Durometer (Shore Hardness) (ISO 868:2003). Available online: https://www.iso.org/standard/34804.html (accessed on 22 September 2020).
- Yanwong, S.; Threepopnatkul, P. Effect of peppermint and citronella essential oils on properties of fish skin gelatin edible films. In Proceedings of the 2015 Global Conference on Polymer and Composite Materials (PCM2015), Beijing, China, 16–18 May 2015; IOP Conference Series: Materials Science and Engineering. IOP Science Publisher: Bristol, UK, 2015; Volume 87, p. 012064. [Google Scholar]
- Romero-Bastida, C.A.; Bello-Pérez, L.A.; García, M.A.; Martino, M.N.; Solorza-Feria, J.; Zaritzky, N.E. Physicochemical and microstructural characterization of films prepared by thermal and cold gelatinization from non-conventional sources of starches. Carbohydr. Polym. 2005, 60, 235–244. [Google Scholar] [CrossRef]
- UNE 53097:2002. Sheet Materials—Determination of Water Vapour Transmission Rate—Gravimetric (Dish) Method. Available online: https://www.iso.org/standard/72382.html (accessed on 22 September 2020).
- Hafsa, J.; Smach, M.A.; Ben Khedher, M.R.; Charfeddine, B.; Limem, K.; Majdoub, H.; Rouatbi, S. Physical, antioxidant and antimicrobial properties of chitosan films containing Eucalyptus globulus essential oil. LWT 2016, 68, 356–364. [Google Scholar] [CrossRef]
- Ungureanu, C.; Ionita, D.; Berteanu, E.; Tcacenco, L.; Zuav, A.; Demetrescu, I. Improving Natural Biopolymeric Membranes Based on Chitosan and Collagen for Biomedical Applications Introducing Silver. J. Braz. Chem. Soc. 2015, 26, 458–465. [Google Scholar] [CrossRef]
- Gülçin, I. Antioxidant activity of food constituents: An overview. Arch. Toxicol. 2011, 86, 345–391. [Google Scholar] [CrossRef] [PubMed]
- Šonje, M.B.; Giacometti, J.; Abram, M. Antioxidant and antilisterial activity of olive oil, cocoa and rosemary extract polyphenols. Food Chem. 2011, 127, 1821–1827. [Google Scholar] [CrossRef]
- Sivakumar, G.; Uccella, N.A.; Gentile, L. Probing Downstream Olive Biophenol Secoiridoids. Int. J. Mol. Sci. 2018, 19, 2892. [Google Scholar] [CrossRef] [PubMed]
- Chimi, H. Olive Oil and Quality. Acta Hortic. 2002, 586, 667–670. [Google Scholar] [CrossRef]
- Franco, J.M.; García-Zapateiro, L.A.; Valencia, C.; Delgado, M.A.; Gallegos, C.; Ruiz-Méndez, M.V. Chemical, thermal and viscous characterization of high-oleic sunflower and olive pomace acid oils and derived estolides. Grasas Y Aceites 2013, 64, 497–508. [Google Scholar] [CrossRef]
- Poiana, M.-A.; Alexa, E.; Munteanu, M.-F.; Gligor, R.; Moigradean, D.; Mateescu, C. Use of ATR-FTIR spectroscopy to detect the changes in extra virgin olive oil by adulteration with soybean oil and high temperature heat treatment. Open Chem. 2015, 13, 689–698. [Google Scholar] [CrossRef]
- Nurwahidah, A.T.; Riyanto, S.R.; Nurrulhidayah, A.F.; Betania, K.; Rohman, A. Fourier Transform Infrared Spectroscopy (FTIR) coupled with multivariate calibration and discriminant analysis for authentication of extra virgin olive oil from rambutan seed fat. Food Res. 2019, 3, 727–733. [Google Scholar] [CrossRef]
- Chiavaro, E.; Rodriguez-Estrada, M.T.; Vittadini, E.; Pellegrini, N. Microwave heating of different vegetable oils: Relation between chemical and thermal parameters. LWT 2010, 43, 1104–1112. [Google Scholar] [CrossRef]
- Lim, H.K.; Tan, C.P.; Karim, R.; Ariffin, A.A.; Bakar, J. Chemical composition and DSC thermal properties of two species of Hylocereus cacti seed oil: Hylocereus undatus and Hylocereus polyrhizus. Food Chem. 2010, 119, 1326–1331. [Google Scholar] [CrossRef]
- Nehdi, I.A.; Hadj-Kali, M.K.; Sbihi, H.M.; Tan, C.P.; Al-Resayes, S.I. Characterization of Ternary Blends of Vegetable Oils with Optimal ω-6/ω-3 Fatty Acid Ratios. J. Oleo Sci. 2019, 68, 1041–1049. [Google Scholar] [CrossRef]
- Pereda, M.; Amica, G.; Marcovich, N.E. Development and characterization of edible chitosan/olive oil emulsion films. Carbohydr. Polym. 2012, 87, 1318–1325. [Google Scholar] [CrossRef]
- Solano, A.C.V.; De Gante, C.R. Development of biodegradable films based on blue corn flour with potential applications in food packaging. Effects of plasticizers on mechanical, thermal, and microstructural properties of flour films. J. Cereal Sci. 2014, 60, 60–66. [Google Scholar] [CrossRef]
- Unilever Food Solutions. 2020. Available online: https://www.unileverfoodsolutions.es/informacion-producto/maizena-harina-fina-de-maiz-sin-gluten-caja-2-5kg-70-ES-101818.html (accessed on 20 July 2020).
- Jha, P.; Dharmalingam, K.; Nishizu, T.; Katsuno, N.; Anandalakshmi, R. Effect of Amylose–Amylopectin Ratios on Physical, Mechanical, and Thermal Properties of Starch-Based Bionanocomposite Films Incorporated with CMC and Nanoclay. Starch Stärke 2019, 72. [Google Scholar] [CrossRef]
- Agama-Acevedo, R.; Juárez, E.G.; Evangelista, S.L.; Rosales, O.L.; Bello, L.A. Characteristics of maize starch and relationship with its biosynthesis enzymes. Agrociencia 2013, 47, 1–12. [Google Scholar]
- Liu, X.; Wang, Y.; Yu, L.; Tong, Z.; Chen, L.; Liu, H.; Li, X. Thermal degradation and stability of starch under different processing conditions. Starch Stärke 2012, 65, 48–60. [Google Scholar] [CrossRef]
- Xiong, H.; Tang, S.; Tang, H.; Zou, P. The structure and properties of a starch-based biodegradable film. Carbohydr. Polym. 2008, 71, 263–268. [Google Scholar] [CrossRef]
- Kibar, E.A.A.; Us, F. Thermal, mechanical and water adsorption properties of corn starch–carboxymethylcellulose/methylcellulose biodegradable films. J. Food Eng. 2013, 114, 123–131. [Google Scholar] [CrossRef]
- Basiak, E.; Debeaufort, F.; Lenart, A. Effect of oil lamination between plasticized starch layers on film properties. Food Chem. 2016, 195, 56–63. [Google Scholar] [CrossRef]
- Chen, H.; Yuan, Y.; Li, Q. Preparation and Characterization of Corn Starch-Based Composite Films Containing Corncob Cellulose and Cassia Oil. Starch Stärke 2020, 72, 1900209. [Google Scholar] [CrossRef]
- Farajpour, R.; Djomeh, Z.E.; Moeini, S.; Tavahkolipour, H.; Safayan, S. Structural and physico-mechanical properties of potato starch-olive oil edible films reinforced with zein nanoparticles. Int. J. Biol. Macromol. 2020, 149, 941–950. [Google Scholar] [CrossRef]
- Ruiz-Navajas, Y.; Viuda-Martos, M.; Sendra, E.; Pérez-Alvarez, J.A.; Fernández-López, J. In vitro antibacterial and antioxidant properties of chitosan edible films incorporated with Thymus moroderi or Thymus piperella essential oils. Food Control 2013, 30, 386–392. [Google Scholar] [CrossRef]

| Parameter | Control | OE 0.05 | OE 0.1 | OE 0.2 |
|---|---|---|---|---|
| Thickness (mm) | 0.09 ± 0.01 a | 0.09 ± 0.02 a | 0.10 ± 0.01 a | 0.11 ± 0.01 a |
| L* | 64.58 ± 0.01 a | 60.27 ± 0.01 b | 62.09 ± 0.01 c | 57.59 ± 0.02 d |
| a* | −1.27 ± 0.04 a | −0.62 ± 0.02 b | 1.17 ± 0.02 c | 3.26 ± 0.04 d |
| b* | 5.41 ± 0.03 a | 10.33 ± 0.04 b | 15.66 ± 0.02 c | 18.76 ± 0.01 d |
| ΔE | −3.63 ± 0.09 a | −0.99 ± 0.02 b | 1.20 ± 0.02 c | 3.01 ± 0.04 d |
| WI | 64.15 ± 0.01 a | 58.95 ± 0.01 b | 58.97 ± 0.01 b | 53.52 ± 0.02 c |
| Formulation | ΔHm (J g−1) | Tm (°C) | Tg (°C) | TPeak 1 (°C) | TPeak 2 (°C) | T Peak 3 (°C) | T Peak 4 (°C) |
|---|---|---|---|---|---|---|---|
| Control | 68 ± 1 a | 214 ± 1 a | −63 ± 2 a | 82 ± 6 a | 220 ± 2 a | 310 ± 6 a | 480 ± 2 a |
| OE 0.05 | 69 ± 4 a | 220 ± 2 a | −66 ± 2 a | 79 ± 4 a | 221 ± 2 a | 316 ± 3 a | 482 ± 2 a |
| OE 0.1 | 66 ± 1 a | 220 ± 1 a | −63 ± 2 a | 77 ± 5 b | 220 ± 1 a | 312 ± 1 a | 476 ± 5 a |
| OE 0.2 | 68 ± 5 a | 214 ± 4 a | −59 ± 5 a | 76 ± 4 c | 225 ± 3 a | 312 ± 1 a | 479 ± 3 a |
| Property | Control | OE 0.05 | OE 0.1 | OE 0.2 |
|---|---|---|---|---|
| Young’s modulus (MPa) | 3.4 ± 0.1 a | 4.1 ± 0.1 b | 4.6 ± 1.0 b | 2.1 ± 0.2 c |
| Elongation at break (%) | 67 ± 3 a | 42 ± 1 b | 41± 7 b,c | 47± 2 d |
| Shore D hardness | 76.21 ± 0.01 a | 64.20 ± 0.02 b | 54.42 ± 0.03 c | 46.84 ± 0.01 d |
| Moisture content (%) | 7.3 ± 0.2 a | 7.3 ± 0.4 a | 6.4 ± 0.8 a | 6.9 ± 0.4 a |
| OTR (cm3 mm m−2 day) | 0.49 ± 0.02 a | 0.41 ± 0.07 a | 0.40 ± 0.08 a | 0.38 ± 0.09 a |
| WVP × 10−4 (Kg m Pa−1 s−1 m−2) | 23 ± 2 a | 33 ± 5 b | 24 ± 1 a | 15 ± 2 c |
| Formulation | DPPH (%) | ABTS (%) | FRAP (%) | Tini5% (°C) | OOT (°C) |
|---|---|---|---|---|---|
| Control | 0.71 ± 0.25 a | 0.69 ± 0.17 a | 0.07 ± 1.38 a | 102 ± 7 a | 123 ± 3 a |
| OE 0.05 | 22.42 ± 0.17 b | 99.38 ± 0.22 b | 16.30 ± 3.62 b | 110 ± 6 a | 156 ± 3 b |
| OE 0.1 | 94.00 ± 1.00 c | 99.67 ± 0.11 b | 74.25 ± 1.35 c | 137 ± 9 b | 178 ± 1 c |
| OE 0.2 | 96.02 ± 0.53 d | 99.61 ± 0.11 b | 89.38 ± 0.09 d | 152 ± 1 c | 175 ± 1 c |
| Formulation | E. coli | S. aureus |
|---|---|---|
| Control | 0.159 ± 0.009 a | 0.192 ± 0.004 a |
| OE 0.05 | 0.153 ± 0.002 a | 0.166 ± 0.002 a,b |
| OE 0.1 | 0.149 ± 0.008 a | 0.136 ± 0.019 b |
| OE 0.2 | 0.143 ± 0.006 b | 0.105 ± 0.001 c |
© 2020 by the authors. Licensee MDPI, Basel, Switzerland. This article is an open access article distributed under the terms and conditions of the Creative Commons Attribution (CC BY) license (http://creativecommons.org/licenses/by/4.0/).
Share and Cite
García, A.V.; Álvarez-Pérez, O.B.; Rojas, R.; Aguilar, C.N.; Garrigós, M.C. Impact of Olive Extract Addition on Corn Starch-Based Active Edible Films Properties for Food Packaging Applications. Foods 2020, 9, 1339. https://doi.org/10.3390/foods9091339
García AV, Álvarez-Pérez OB, Rojas R, Aguilar CN, Garrigós MC. Impact of Olive Extract Addition on Corn Starch-Based Active Edible Films Properties for Food Packaging Applications. Foods. 2020; 9(9):1339. https://doi.org/10.3390/foods9091339
Chicago/Turabian StyleGarcía, Arantzazu Valdés, Olga B. Álvarez-Pérez, Romeo Rojas, Cristobal N. Aguilar, and María Carmen Garrigós. 2020. "Impact of Olive Extract Addition on Corn Starch-Based Active Edible Films Properties for Food Packaging Applications" Foods 9, no. 9: 1339. https://doi.org/10.3390/foods9091339
APA StyleGarcía, A. V., Álvarez-Pérez, O. B., Rojas, R., Aguilar, C. N., & Garrigós, M. C. (2020). Impact of Olive Extract Addition on Corn Starch-Based Active Edible Films Properties for Food Packaging Applications. Foods, 9(9), 1339. https://doi.org/10.3390/foods9091339

